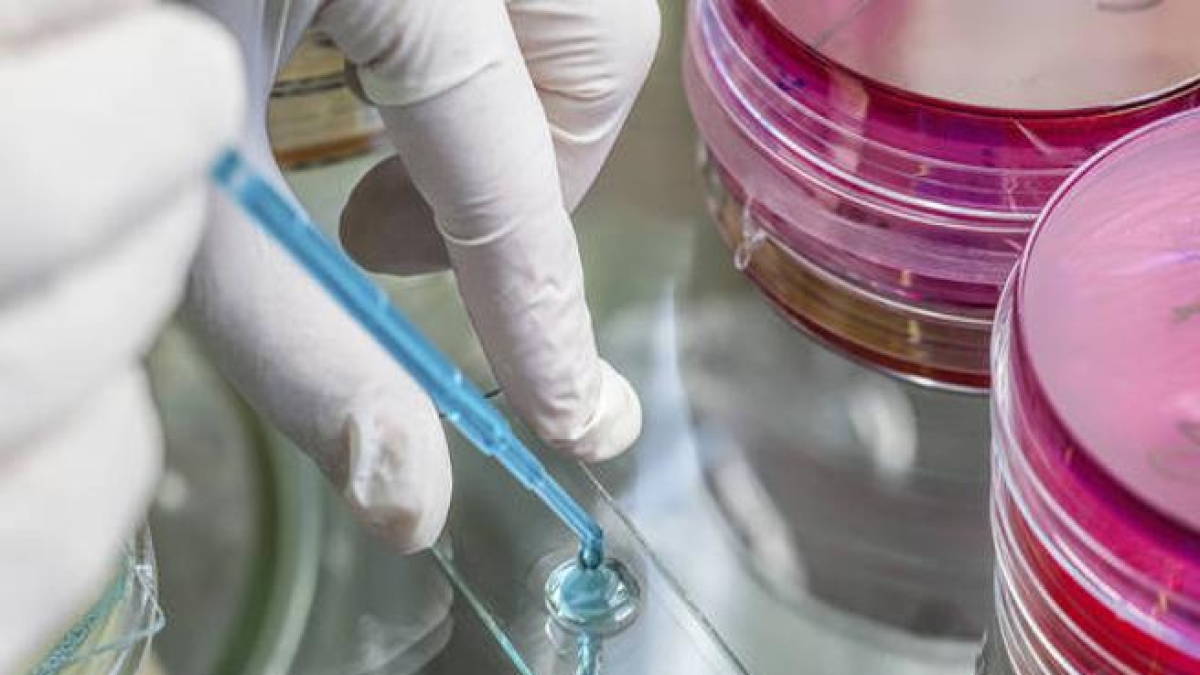
Stitichezza, secondo gli scienziati una vitamina aiuta a risolvere il problema. Ecco in quali cibi è contenuta

di
Giuseppe Di Bisceglie
Lo studio, coordinato dal professor Mauro Damato dell’Università LUM di Casamassima, provincia di Bari e del centro spagnolo CIC bioGUNE, apre scenari inediti per il trattamento di patologie comuni e invalidanti
La chiave per risolvere i disturbi della motilità intestinale potrebbe trovarsi in una molecola che già portiamo a tavola ogni giorno. Un’importante ricerca internazionale, pubblicata sulla prestigiosa rivista scientifica Gut, ha identificato un legame diretto tra la frequenza della defecazione e la vitamina B1, nota anche come tiamina. Lo studio, coordinato dal professor Mauro Damato dell’Università LUM di Casamassima e del centro spagnolo CIC bioGUNE, apre scenari inediti per il trattamento di patologie comuni e invalidanti come la stitichezza, la diarrea e la sindrome dell’intestino irritabile.
Il team di ricerca è giunto a queste conclusioni attraverso un’analisi genomica complessa, denominata multiancestry GWAS, condotta su un campione di circa 270.000 individui di origine europea e asiatica. L’obiettivo era isolare le varianti del DNA responsabili delle differenze nel ritmo intestinale. Tra le ventuno regioni del genoma identificate, dieci delle quali precedentemente ignote alla scienza, spiccano i geni SLC35F3 e XPR1. Questi segmenti genetici sono strettamente legati al metabolismo della vitamina B1, suggerendo che la capacità dell’organismo di gestire questa sostanza influenzi direttamente la velocità con cui l’intestino elabora i rifiuti.
Per validare l’intuizione genetica, gli scienziati hanno incrociato i dati con le abitudini alimentari di 100.000 partecipanti alla UK Biobank. Il riscontro è stato netto: i soggetti con una dieta ricca di tiamina mostrano una frequenza di evacuazione superiore. La tiamina agisce come un carburante essenziale per le cellule, partecipando alla conversione del glucosio in energia e garantendo il corretto tono muscolare delle pareti intestinali. Essendo una vitamina idrosolubile, non viene accumulata dal corpo; deve dunque essere assunta regolarmente attraverso alimenti come legumi, cereali integrali, uova, lievito e carne di maiale.
La scoperta diventa una potenziale rampa di lancio per nuovi protocolli clinici. Attualmente, la regolarità ideale è considerata di una o due volte al giorno, parametro associato a un microbioma equilibrato e a uno stato di salute generale ottimale. Il professor Damato ha sottolineato come questi risultati offrano “piste testabili” per la prossima fase della ricerca, che includerà studi clinici mirati per verificare se l’integrazione specifica di vitamina B1 possa effettivamente sostituire o affiancare i trattamenti tradizionali per la sindrome dell’intestino irritabile. Nonostante l’assenza di rischi da sovradosaggio, poiché l’eccesso viene espulso per via urinaria, gli esperti raccomandano di non modificare il proprio regime dietetico senza il parere di un medico o di uno specialista.
Vai a tutte le notizie di Bari
Iscriviti alla newsletter del Corriere del Mezzogiorno Puglia
27 gennaio 2026 ( modifica il 27 gennaio 2026 | 10:59)
© RIPRODUZIONE RISERVATA